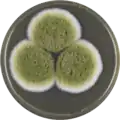
Aspergillus pseudocaelatus growing on MEAOX plate

| Aspergillus pseudocaelatus | |
|---|---|
| Scientific classification | |
| Domain: | Eukaryota |
| Kingdom: | Fungi |
| Division: | Ascomycota |
| Class: | Eurotiomycetes |
| Order: | Eurotiales |
| Family: | Aspergillaceae |
| Genus: | Aspergillus |
| Species: | A. pseudocaelatus |
| Binomial name | |
| Aspergillus pseudocaelatus Varga, Frisvad & Samson, 2011[1] | |
Aspergillus pseudocaelatus is a species of fungus in the genus Aspergillus. It was first isolated from an Arachis burkartii leaf in Argentina. It is most related to the non-aflatoxin producing Aspergillus caelatus, producing aflatoxins B and G, as well as cyclopiazonic acid and kojic acid.[1]
Growth and morphology
A. pseudocaelatus has been cultivated on both Czapek yeast extract agar (CYA) plates and Malt Extract Agar Oxoid® (MEAOX) plates. The growth morphology of the colonies can be seen in the pictures below.
 Aspergillus pseudocaelatus growing on CYA plate
Aspergillus pseudocaelatus growing on CYA plate Aspergillus pseudocaelatus growing on MEAOX plate
Aspergillus pseudocaelatus growing on MEAOX plate
References
Further reading
- Lakkireddy K, Kasturi K, KRS SR (2014). "Aflatoxins in Food and Feed: The Science of Safe Food" (PDF). Practice. 3: 5.
- Andersson, Ellinor (2012). "A small growth study of Aspergillus section Flavi, and potentially aflatoxigenic fungi and aflatoxin occurrence in Brazil nuts from local markets in Manaus, Brazil" (PDF). Uppsala: SLU, Dept. of Microbiology. urn:nbn:se:slu:epsilon-s-1782.
This article is issued from Wikipedia. The text is licensed under Creative Commons - Attribution - Sharealike. Additional terms may apply for the media files.